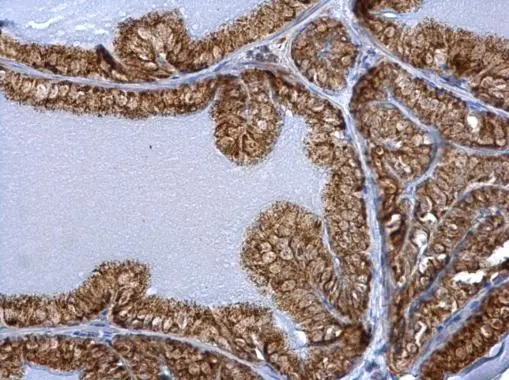
ERAB antibody detects ERAB protein at mitochondria on mouse prostate by immunohistochemical analysis. Sample: Paraffin-embedded mouse prostate. ERAB antibody (GTX100301) dilution: 1:500. 
 Antigen Retrieval: Trilogy? (EDTA based, pH 8.0) buffer, 15min
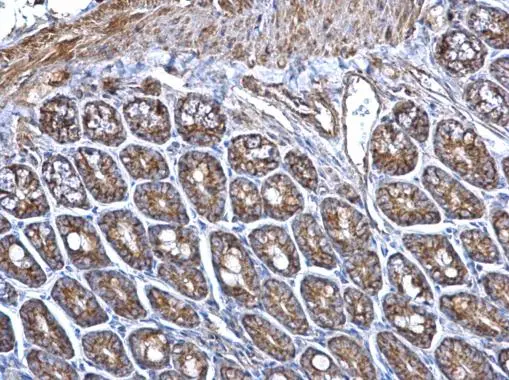
ERAB antibody detects ERAB protein at mitochondria on mouse intestine by immunohistochemical analysis. Sample: Paraffin-embedded mouse intestine. ERAB antibody (GTX100301) dilution: 1:500. 
 Antigen Retrieval: Trilogy? (EDTA based, pH 8.0) buffer, 15min

ERAB antibody detects ERAB protein on whole-mount zebrafish embryos by immunohistochemical analysis. Sample: Paraformaldehyde-fixed zebrafish embryos. ERAB antibody (GTX100301) dilution: 1:200.
ERAB antibody
GTX100301
ApplicationsImmunoFluorescence, Western Blot, ImmunoCytoChemistry, ImmunoHistoChemistry, ImmunoHistoChemistry Paraffin
Product group Antibodies
ReactivityHuman, Mouse, Rat, Zebra Fish
TargetHSD17B10
Overview
- SupplierGeneTex
- Product NameERAB antibody
- Delivery Days Customer9
- Application Supplier NoteWB: 1:1000-1:10000. ICC/IF: 1:100-1:1000. IHC-P: 1:100-1:1000. *Optimal dilutions/concentrations should be determined by the researcher.Not tested in other applications.
- ApplicationsImmunoFluorescence, Western Blot, ImmunoCytoChemistry, ImmunoHistoChemistry, ImmunoHistoChemistry Paraffin
- CertificationResearch Use Only
- ClonalityPolyclonal
- Concentration1 mg/ml
- ConjugateUnconjugated
- Gene ID3028
- Target nameHSD17B10
- Target descriptionhydroxysteroid 17-beta dehydrogenase 10
- Target synonyms17b-HSD10, ABAD, CAMR, DUPXp11.22, ERAB, HADH2, HCD2, HSD10MD, MHBD, MRPP2, MRX17, MRX31, MRXS10, SCHAD, SDR5C1, 3-hydroxyacyl-CoA dehydrogenase type-2, 3-hydroxy-2-methylbutyryl-CoA dehydrogenase, AB-binding alcohol dehydrogenase, amyloid-beta peptide binding alcohol dehydrogenase, endoplasmic reticulum-associated amyloid beta-peptide-binding protein, mitochondrial RNase P subunit 2, mitochondrial ribonuclease P protein 2, short chain L-3-hydroxyacyl-CoA dehydrogenase type 2, short chain type dehydrogenase/reductase XH98G2
- HostRabbit
- IsotypeIgG
- Protein IDQ99714
- Protein Name3-hydroxyacyl-CoA dehydrogenase type-2
- Scientific DescriptionThis gene encodes 3-hydroxyacyl-CoA dehydrogenase type II, a member of the short-chain dehydrogenase/reductase superfamily. The gene product is a mitochondrial protein that catalyzes the oxidation of a wide variety of fatty acids, alcohols, and steroids. The protein has been implicated in the development of Alzheimers disease, and mutations in the gene are the cause of 2-methyl-3-hydroxybutyryl-CoA dehydrogenase deficiency (MHBD). Several alternatively spliced transcript variants have been identified, but the full-length nature of only two transcript variants has been determined. [provided by RefSeq]
- ReactivityHuman, Mouse, Rat, Zebra Fish
- Storage Instruction-20°C or -80°C,2°C to 8°C
- UNSPSC12352203